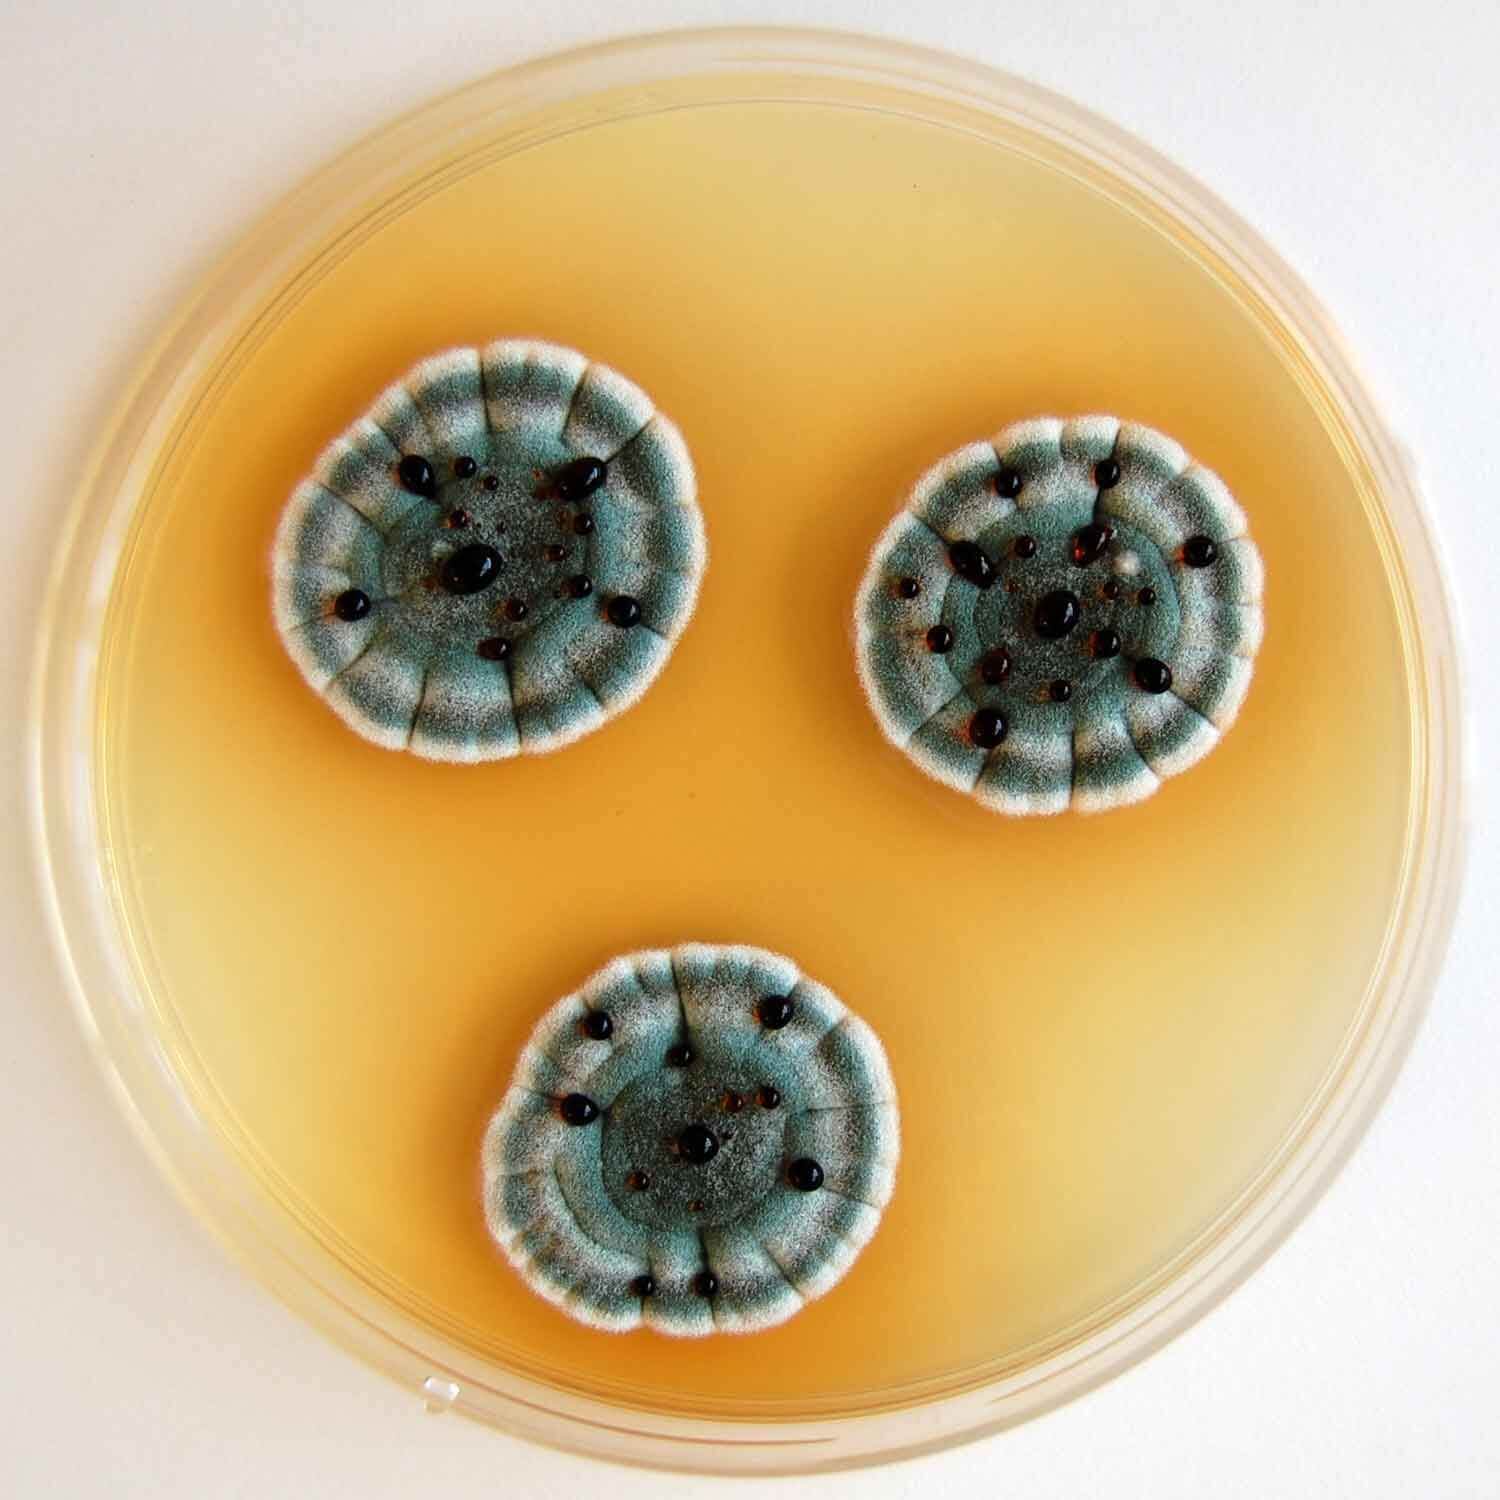

КАК ВЫБРАТЬ ПЕРВЫЙ МИКРОСКОП?
Изучать в микроскоп окружающий нас невидимый мир, его устройство и обитателей очень интересно и познавательно. Но для этого нужно правильно подобрать микроскоп, тогда он прослужит долго и всегда пригодится в будущем.
ИЗ ЧЕГО СОСТОИТ МИКРОСКОП?
Чтобы правильно выбрать свой первый микроскоп, нужно обладать хотя бы минимальными знаниями об его устройстве. Любой микроскоп состоит:

- Из окуляра. В него смотрит наблюдатель. Располагается окуляр на тубусе.
- Из объектива. Как правило у микроскопа три объектива, и они имеют разное увеличение.
- Из предметного столика. На нем размещают предмет исследования или предметное стеклышко для изучения прозрачных предметов.
- Из осветителя. Он находится под предметным столиком и служит для освещения прозрачных объектов. В простейших моделях вместо осветителя используется зеркальце. Некоторые микроскопы имеют дополнительный верхний осветитель. С ним можно рассматривать также и непрозрачные предметы.
- Из рукояток настройки. Расположены по бокам штатива для настраивания резкого изображения.
- Из штатива, на котором все это установлено.
КАКИЕ БЫВАЮТ МИКРОСКОПЫ?
Совсем универсальных микроскопов не существует. И в зависимости от того, что вы будете рассматривать, нужно подобрать тип, или как принято говорить в микроскопии – строение микроскопа, которое лучше всего подойдет именно вам. Ведь в микроскоп можно изучать самые разные объекты - ткани растений и животных, клеточные структуры, простейшие организмы, водоросли, бактерии, минералы и кристаллы. И насекомых, растения, камни, металлы, электронные платы и многое другое. Разнообразие объектов исследования влияет на то, каким должен быть микроскоп.
Прямые микроскопы
Слева микроскоп Микромед Эврика 40x-400x – это классическая модель микроскопа. Это «прямой» микроскоп. Об этом говорят объективы, расположенные сверху, над предметным столиком. Такой микроскоп доставит радость детям и принесет пользу исследователям постарше. Несмотря на небольшую цену, этот микроскоп оснащен стеклянной оптикой высокого качества позволяющей проводить исследования с увеличениями от 40 до 400 крат. Он оборудован двумя осветителями, поэтому с его помощью можно исследовать и прозрачные и непрозрачные предметы. Этот микроскоп один из самых универсальных.

Стереомикроскопы
Если хочется рассматривать крупные объемные предметы, то больших увеличений не потребуется, и нужно обратить внимание на стереомикроскопы. В середине на картинке стереомикроскоп Микромед Атом 20х. Главная особенность такого микроскопа в том, что он позволяет наблюдать объемное изображение, таким, как его видят глаза человека.

Этот микроскоп может увидеть огромный участок предмета шириной целых 9 мм, а высота исследуемого предмета может достигать 30 мм! Два осветителя позволяют исследовать как прозрачные объекты, например крылышки насекомых или срезы растений, так и непрозрачные – кристаллы, монетки, минералы, электронные платы или насекомых.
Благодаря двум окулярам при наблюдении не нужно зажмуривать один глаз - наблюдение ведется обоими глазами что позволяет достоверно видеть глубину изучаемого предмета.
Увеличение микроскопа 20 крат оптимально для таких исследований – при больших увеличениях потеряется стереоэффект, да и вместо целой божьей коровки вы будете видеть только её головку, как на фото ниже.
Инвертированные микроскопы
Этот необычный микроскоп справа на картинке. Он называется Микромед Эврика 40х-320х и выглядит непривычно, потому что этот микроскоп «инвертированный». Или – перевернутый. Также, как и традиционный микроскоп, он имеет объектив, окуляр и осветитель. Но в отличие от обычного микроскопа, объектив находится снизу, под столиком с наблюдаемым предметом, а источник света расположен сверху.
Колонии плесени в чашке Петри.
Такие микроскопы предназначены для биологических исследований, которые должны проводиться в жидкой питательной среде и поэтому для них требуется специальная посуда – чашки Петри. Чашка имеет прозрачное дно и устанавливается на столик, а ее содержимое рассматривается снизу.
Изучать жизнь и развитие микроорганизмов в среде их обитания очень увлекательное занятие. О том, как подготовиться к таким исследованиям можно прочитать в нашей статье.
С помощью этого микроскопа можно исследовать и обычные препараты - для этого предназначены зажимы для предметного стекла на столике.
КАК РАССЧИТАТЬ УВЕЛИЧЕНИЕ?
Увеличение оптического микроскопа = увеличение окуляра х увеличение объектива.
Увеличение измеряется в «кратах» и обозначается буквой «Х». Его величина часто наносится и на окуляр и на объектив. Например, имея окуляр 10х и объектив 40х увеличение микроскопа составит 400х. Для подавляющего большинства исследований достаточно комплекта из 3-х объективов входящих в комплект к микроскопу.
КАКОЕ УВЕЛИЧЕНИЕ ПОТРЕБУЕТСЯ?
Начинающему исследователю не нужно гнаться за большими увеличениями – для большинства случаев достаточно 20 – 400 крат. При больших увеличениях картинка может становится темной и мутной. Расстояние до объекта при больших увеличениях становится очень маленьким, и при неосторожном движении можно легко раздавить стеклышко, пораниться и испортить объектив. Это требует повышенного внимания.

Божья коровка с увеличением 20 и 50 крат.
КАКОЙ НУЖЕН ОСВЕТИТЕЛЬ?
Качественное освещение в микроскопии имеет огромное значение независимо от того, какой это микроскоп – дорогой профессиональный, или бюджетный детский. Наличие у микроскопа двух осветителей позволит рассматривать не только прозрачные, но и непрозрачные предметы. Если же вы твердо убеждены, что будете исследовать только прозрачные объекты, например, срезы тканей, то достаточно только нижнего осветителя для проходящего света. В любом случае светодиодный осветитель предпочтительнее осветителя с лампочкой. Простейшие же модели с зеркальцем ставит наблюдателя в зависимость от условий освещения, заставляя постоянно ловить отраженный свет или использовать яркий дополнительный светильник.
НЕМНОГО ПРО ЭРГОНОМИКУ
- Правильно подобранный микроскоп должен быть удобен в использовании. Купив неудобный микроскоп или сэкономив, можно добиться разочарования ребенка, а это может оттолкнуть его навсегда от желания изучать увлекательный микромир.
- Правильная высота микроскопа должна составлять 25 – 30 см до окуляра. Наклонный тубус окуляра наиболее удобен и комфортен для наблюдения.
- Микроскоп должен быть устойчивым и желательно с металлическим штативом, потому что хлипкий пластик подвержен деформации и очень трудно навестись на резкость, особенно при больших увеличениях. Стоит только дотронуться до винта настройки фокусировки – и резкость уплывает. А это тоже приводит к разочарованию.
САМЫМ МАЛЕНЬКИМ
Самым юным исследователям радость и ощущение игры доставят разноцветные микроскопы – всегда можно сделать подарок ребенку в его любимом цвете. Например, прямой детский микроскоп Микромед Атом 40х-640х выпускается в четырех цветах – аметист, лайм, апельсин и лазурь. Но это не игрушка, а настоящий исследовательский инструмент с тремя объективами и светодиодным осветителем!

И В ЗАКЛЮЧЕНИЕ
Мы рассказали о том, как подобрать первый микроскоп на примерах самых популярных моделей бюджетных микроскопов. Конечно, есть и более продвинутые модели со специальной системой подсветки образцов, с подвижками препаратов вращением ручек, со встроенными цифровыми камерами и прочими хитростями. Их лучше всего покупать, когда ребенок точно определился с кругом своих исследовательских интересов. Для начала же будет разумно приобрести самую простую и качественную модель микроскопа.
В нашем интернет-магазине и у наших дилеров Вы всегда найдёте обширный выбор различных моделей микроскопов. Микроскоп также можно купить в наших салонах в Санкт-Петербурге или Москве.
Мы всегда рады предложить Вам качественный и надёжный инструмент торговых марок Микромед!




























































